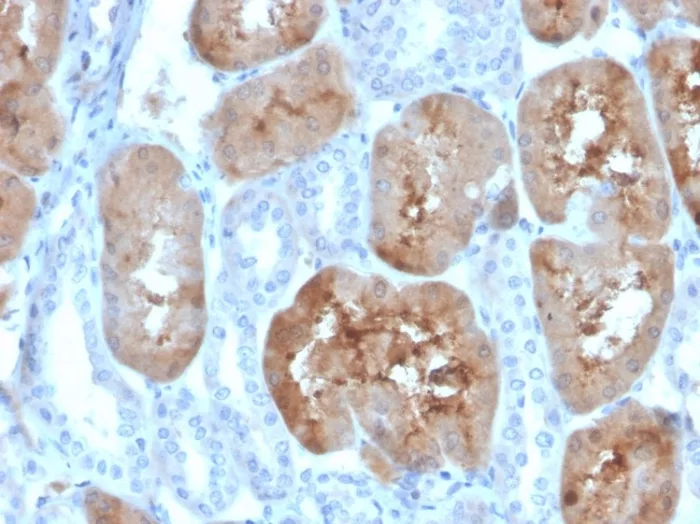

Western Blot Analysis of human kidney tissue lysate using FABP1 Mouse Monoclonal Antibody (FABP1/4519).

SDS-PAGE Analysis of Purified FABP1 Mouse Monoclonal Antibody (FABP1/4519). Confirmation of Purity and Integrity of Antibody.
Formalin-fixed, paraffin-embedded human kidney stained with FABP1 Mouse Monoclonal Antibody (FABP1/4519). HIER: Tris/EDTA, pH9.0, 45min. 2°C: HRP-polymer, 30min. DAB, 5min.

Analysis of Protein Array containing more than 19,000 full-length human proteins using FABP1-Monospecific Mouse Monoclonal Antibody (FABP1/4519). Z- and S- Score: The Z-score represents the strength of a signal that a monoclonal antibody (MAb) (in combination with a fluorescently-tagged anti-IgG secondary antibody) produces when binding to a particular protein on the HuProtTM array. Z-scores are described in units of standard deviations (SD's) above the mean value of all signals generated on that array. If targets on HuProtTM are arranged in descending order of the Z-score, the S-score is the difference (also in units of SD's) between the Z-score. S-score therefore represents the relative target specificity of a MAb to its intended target. A MAb is considered to specific to its intended target, if the MAb has an S-score of at least 2.5. For example, if a MAb binds to protein X with a Z-score of 43 and to protein Y with a Z-score of 14, then the S-score for the binding of that MAb to protein X is equal to 29.
Fatty acid-binding proteins, designated FABPs, are a family of homologous cytoplasmic proteins that are expressed in a highly tissue-specific manner and play an integral role in the balance between lipid and carbohydrate metabolism. FABPs mediate fatty acid (FA) and/or hydrophobic ligand uptake, transport and targeting within their respective tissues. The mechanisms underlying these actions can give rise to both passive diffusional uptake and protein-mediated transmembrane transport of FAs. FABPs are expressed in adipocytes (A-FABP), brain (B-FABP), epithelium (E-FABP, psoriasis-associated FABP, PA-FABP), striated muscle and heart (H-FABP, mammary-derived growth inhibitor or MDGI), intestine (I-FABP), liver (L-FABP or FABP1), myelin (M-FABP) and testis (T-FABP). FABP1 (L-FABP) expression is modulated by developmental, hormonal, dietary and pharmacological factors, and is required for cholesterol synthesis and metabolism.
There are no reviews yet.